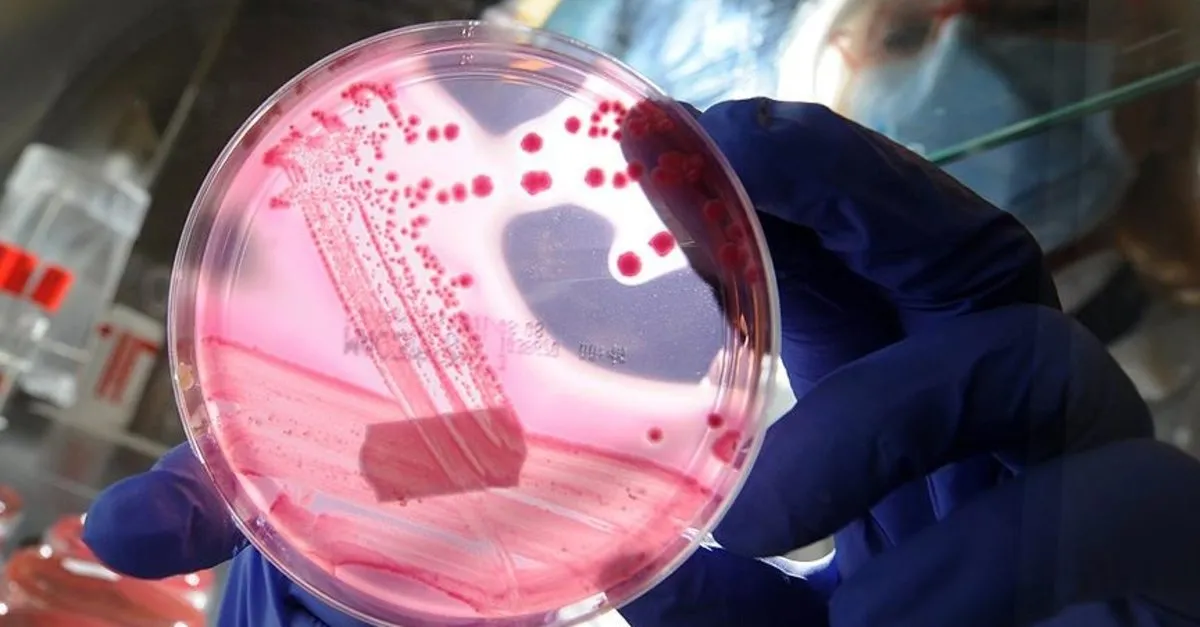

sma taraması nedir
uzay kirliliği nedir usta sanatçı vefat etti uzay fotoğrafı uvex ayakkabı uzay roketi çizimi uyku aknesi uyku getiren yiyecek ve içecekler uyku hikayeleri uykusuzluk nasıl geçer uyku gelmemesi için ne yapılır

şükrü baba مواقيت الصلاة في اسطنبول 2020 şıngıl nasıl döşenir şükran özer doruk şık mutfak modelleri şuursuz aşk izle şurfa ezan vakitler 2020
3

J1iax02mjlhvim

Sma Spinal Muskuler Atrofi Nedir Sma Testi Neden Ve Nasil Yapilir Iste Cevabi Saglik Haberleri

Pd8go89kn7z8gm

Sma Taramasi Nedir Sma Tarama Testi Zorunlu Mu Saglik Haberleri Ntv

Agustos Sma Farkindalik Ayidir Kasder

O4bbfdwi8icmfm

Sma Taramasi Nedir Sma Nedir Neden Olur Sma Tedavisi Var Mi Saglik Haberleri

1 Ocak 2020 Tarihine Kadar Ucretsiz Sma Tasiyicilik Testi

Saglik Bakanligi Evlenecek Ciftlere Ucretsiz Sma Taramasi Yapacak

Sma Testi Nedir Sma Taramasi Neden Yapilir Kimlere Yapilir Ucretsiz Mi Sonhaberler

Ifimqqbzdm5edm

Sma Hastaligi Nedir Belirtileri Nedenleri Ve Tedavisi Neler Saglik Son Dakika Haberler

0kxcyvh1xziowm

Genetik Tarama Ile Sma Yi Onceden Tespit Etmek Mumkun

Vatjpxd1u Culm

3okcxnr2 U79zm

7gnhlmc0kaxb7m

Ucretsiz Sma Tasiyicilik Taramasi

Sma Tarama Testi Nedir Nasil Yapilir Evlilik Oncesi Ucretsiz Sma Testi Gundemde Son Dakika Haberleri Internet

Evlilik Oncesinde Sma Taramasi Zorunlu Hale Getirilecek Bianet

J9syblifa1gngm

918synon3rpeqm

Oai Plrbztmftm

Ijewaschjwy5mm
Lniu0nfdkhdmhm

Sma Tasiyici Testi Ucreti 2021 Istanbul Laboratuvarlari

Sma Ile Mucadele Eden Anneden Devlete Evlilik Oncesi Tarama Testi Cagrisi

Fp0gvybrwat05m

Evlenmeden Once Sma Tasiyicilik Taramasi Yapilmali

Sma Hastaligi Nedir Belirtileri Neler Sma Taramasi Nedir Ve Hastalik Kimler Gorulur Saglik Haberleri

O4bbfdwi8icmfm

Gqitbyulmhyg1m

Zhkfu08cld2r4m

Sma Ile Mucadele Eden Anneden Devlete Evlilik Oncesi Tarama Testi Cagrisi

8exbghyplvmihm

2 Zouglfcx2em

217 Stk Ve Sendikadan Cagri Sma Tedavisi Sgk Kapsamina Alinsin Saglik Son Dakika Haberler

Yjdle3ge9w0o3m
